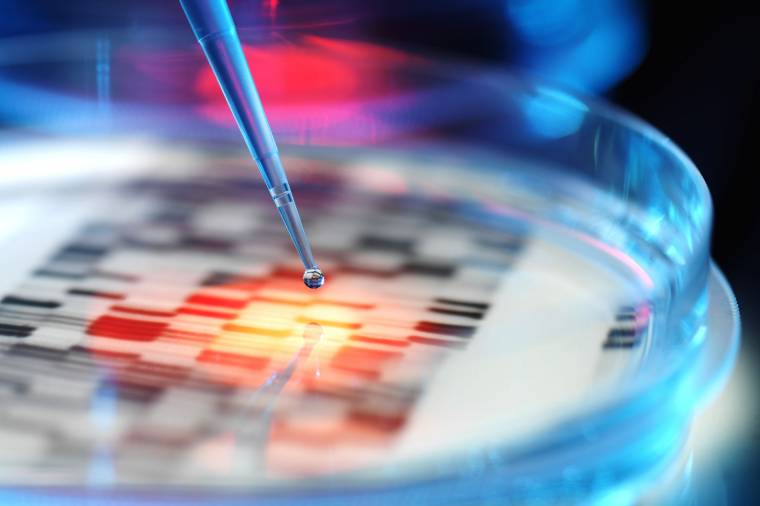
Emberi embriók génszerkesztését engedélyezték brit kutatóknak

Hivatalosan is megünneplik Romániában november 19-én a férfiak napját, valamint március 8-án a nők napját – az erre vonatkozó törvényt szerdán fogadta el a képviselőház.
Tarzan világhírű alakjának megformálója, Johnny Weissmüller bánsági sváb származású amerikai olimpiai úszóbajnok, filmszínész alakja köré szerveződik az az összetett turisztikai csomag, amelyet a színész szülővárosában, Temesváron kezdeményeznek.

Emberi embriók génszerkesztéséhez kaptak engedélyt brit kutatók. A Francis Crick Intézetben induló munka az emberi élet legelső napjait kutatja – számolt be róla a BBC hírportálja.
A népi hiedelmet alapul véve egy „medvebarlanghoz” látogatottunk el, ahol arra voltunk kíváncsiak, vajon előjön-e a téli álmot alvó vad gyertyaszentelő napján megnézni, van-e árnyéka.

Mégis életben van az a két újszülött, akit császármetszéssel hoztak világra az orvosok Szolnokon, miután édesanyjuk kábítószert fogyasztott múlt héten. A hírt az egyik nő nagymamája erősítette meg az MTI-nek hétfőn.

A sertésinfluenza Romániába való átterjedésétől tartanak a hatóságok, miután a Suceava megyével határos ukrajnai régióban több megbetegedést jegyeztek.

Hagyományos farsangi alakoskodást rendeztek a Maros megyei Kibéden, ahol a népszokást megörökítő fotózás három évtizedes történetéből nyílt kiállítás.

Korhatárossá tenné a dohányzós jeleneteket bemutató filmeket, mint „a dohánytermékek promóciójának utolsó bástyáját” az Egészségügyi Világszervezet (WHO).

Meghalt mindkét kábítószerező törökszentmiklósi nő császármetszéssel világra hozott újszülöttje - erősítette meg a családok ismerőse hétfőn az MTI-nek az RTL Klub és a Szóljon.hu információit. Az újszülötteket a fővárosi Semmelweis Egyetemen látták el.

Ismert rock- és blueselőadók mellett fiatal zenészek emlékeznek Radics Bélára, a 70 éve született gitárkirályra február 6-án a budapesti Angyalföldön, a József Attila Művelődési Központban.

Sorra tekeredtek ki a finomabbnál finomabb ízesítésű kolbászok a töltőkből szombat délelőtt Csíkszentmiklóson, ahol a helyi ifjúsági szervezet harmadik alkalommal szervezte meg a kolbászfesztivált.

A Kállay Saunders Band nyerte A Dal második elődöntőjét szombaton. A zsűri döntésével még Oláh Gergő, Vásáry André, Gáspár Laci, a Karmapolis és Szécsi Böbe, a tévénézők szavazataival a Passed jutott tovább a középdöntőbe.

A csángó bál a nemzeti összetartozás kulturális kifejeződése, a csángók művészete nemcsak minket, magyarokat gazdagít, hanem egész Európát – emelte ki Trócsányi László, igazságügyi miniszter a XX. Csángó Bálon szombaton Budapesten.

Az egészen egyedülálló nyelvi és néphagyományokkal bíró csángó kultúra népszerűsítése és a csángó magyarok támogatása a célja a Budapesten szombaton megrendezendő Csángó Bálnak – emelte ki Németh Zsolt, az Országgyűlés külügyi bizottságának elnöke.

Európába is behozták Latin-Amerikából hazatért utazók a szúnyogok által terjesztett, veszélyes Zika-vírust, amely a várandós anyáknál vetélést, halvaszülést, a babáknál pedig kóros kisfejűséget okoz.

Bár több európai országban – mostantól Romániában is – dohányzási korlátozás van érvényben, ettől függetlenül mindenhol továbbra is működnek a pipaklubok, országos versenyeket, bajnokságokat rendeznek.

A Kossuth Rádió Arcvonások című műsora csütörtöki adásának vendége Rózsa Ferenc szombathelyi művész, zenetudós, aki matematikai tanulmányait hasznosítja a zenekutatásban. Nevét a külhoni zenekedvelők két különleges mű bemutatása nyomán ismerhették meg.

Erdélyben turnézik februárban Dancs Annamari sepsiszentgyörgyi származású énekesnő, a Budapesti Operettszínház szólistája, aki két kollégájával, Janza Katával és Laki Péterrel lép fel több erdélyi és partiumi városban.
